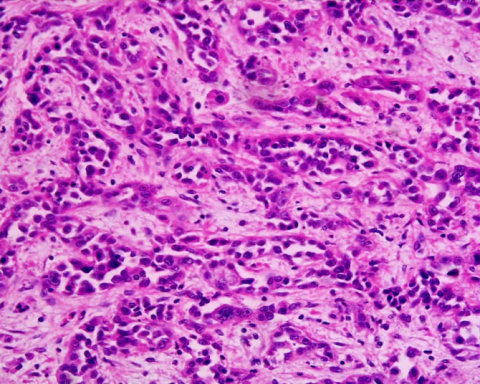

Medicina
El mundo necesita un sistema global para detectar y detener la propagación de enfermedades emergentes en los cultivos
Más del 20 por ciento de los cinco cultivos de primera necesidad que proveen la mitad del consumo de calorías del planeta se pierden cada año a causa de las plagas. El cambio climático y el comercio mundial son factores causales de la propagación, surgimiento y re-surgimiento de enfermedades de los cultivos, y la acción de contención es a menudo ineficiente, especialmente en los países de bajos ingresos. Un Sistema Global de Vigilancia (GSS, por sus siglas en inglés) para fortalecer e interconectar los sistemas de bioseguridad de cultivos podrían tener éxito en mejorar la seguridad alimentaria mundial, argumenta un equipo de expertos en la edición del 28 de junio de Science.
“Como parte de esfuerzos para satisfacer la demanda global de alimentos – que podría significar aumentar la producción agrícola hasta en un 70 por ciento para el año 2050 – necesitamos un GSS para reducir los alimentos que se pierden por causa de las plagas”, afirmó Mónica Carvajal, investigadora del Centro Internacional de Agricultura Tropical (CIAT) y autora principal. “Se requiere de mucha colaboración y discusiones para tomar medidas rápidamente y evitar brotes que pudieran impactar negativamente el comercio y la seguridad alimentaria”.
Carvajal y sus colegas esperan que el marco del GSS que ellos proponen gane impulso en 2020, que fue proclamado por las Naciones Unidas como el Año Internacional de la Sanidad Vegetal. El sistema priorizaría seis cultivos alimenticios principales – maíz, papa, yuca, arroz, fríjol y trigo – así como otros cultivos alimenticios y comerciales importantes que se comercializan entre fronteras. La propuesta del GSS es el resultado de una reunión de carácter científico organizada por el CIAT y realizada en 2018 en el Centro Bellagio de la Fundación Rockefeller en Italia.
En 2015, se descubrió la enfermedad del mosaico de la yuca (CMD) en Camboya, pero los hallazgos fueron publicados hasta 2016. Para 2018, la enfermedad se había propagado a Tailandia y Vietnam, y actualmente se estima que está presente en el 10 por ciento de las superficies cultivadas en la región, amenazando a millones de pequeños productores que cultivan la yuca y generan US$4 mil millones en ingresos por exportación.
![[Img #56239]](https://noticiasdelaciencia.com/upload/images/07_2019/9381_46859.jpg)
La comunidad científica insta a detener la propagación de enfermedades emergentes en los cultivos. (Foto: CIAT)
Este año, autoridades agrícolas de cuatro países – Camboya, Tailandia, Vietnam y RDP Lao – apoyadas por organizaciones de investigación incluido el CIAT, publicaron un plan de control de emergencia para CMD en el sureste de Asia.
Carvajal, quien estudió el brote de CMD tras su reporte inicial, dice que un GSS ayudaría a acelerar las acciones para futuros brotes.
“La pregunta que hice fue por qué toma tanto tiempo responder a enfermedades de cultivos en algunos casos?”, comenta Carvajal. “Cuál es la limitación para responder más rápido desde un principio?”.
La propuesta del GSS parte de lecciones aprendidas del brote del añublo del trigo que golpeó a Bangladesh en 2016 y el brote bacteriano de Xylella fastidiosa que empezó a afectar árboles de olivo en Europa en 2013. La propuesta proviene de un grupo multidisciplinario de expertos de la academia, centros de investigación y organizaciones financiadoras que trabajan sobre temas relacionados con sanidad vegetal y salud humana.
El GSS se enfocaría en reforzar el personal de “vigilancia activa” y “vigilancia pasiva” de las redes, que están al frente de los brotes de enfermedades. La vigilancia activa consta de laboratorios en estaciones de inspección agrícola, e inspectores de aduana y fitosanitarios en las fronteras y puertos de entrada. A pesar de su infraestructura formal, tan solo un estimado de 2–6 por ciento de los cargamentos puede ser analizado de forma efectiva.
El segundo grupo incluye redes separadas de productores, agentes de extensión con organizaciones agrícolas nacionales, científicos y agrónomos en centros de investigación y universidades, y especialistas en industrias agrícolas.
“Para que esta infraestructura sea efectiva, se deben mejorar las conexiones entre los primeros detectores y los que actúan en respuesta al final de la cadena, y se deben coordinar las acciones”, afirman los autores.
“Sin embargo, hacen falta capacidades diagnósticas, compartir información y protocolos de comunicaciones o están deficientemente establecidos en algunas regiones, especialmente en países de bajos ingresos.
Nuestra reflexión sobre muchos brotes de enfermedades es que, bien sea en países de altos o bajos ingresos, la infraestructura de vigilancia pasiva cuenta con el mayor alcance en monitoreo en campo pero la menor coordinación de lo local a lo global”.
El GSS aprovecharía tecnología de vanguardia para emitir diagnósticos rápidos de enfermedades y usaría las redes de comunicaciones, incluidos los medios sociales, para compartir información rápidamente. El sistema tendría nodos regionales y contaría con cinco redes globales formales. Estas incluirían una red de laboratorios diagnósticos, una red de evaluación de riesgos, una red de gestión de datos, una red de manejo operativo y una red de comunicaciones.
“Nuestro equipo es consciente de que existe una problemática grande en cuanto a las comunicaciones, incluso cuando hablamos el mismo idioma y usamos las mismas tecnologías”, dice Carvajal. “Uno de los componentes más relevantes es la red de comunicaciones”.
El equipo de GSS espera contribuir a esfuerzos futuros para el fortalecimiento de sistemas de respuesta frente a brotes de plagas dentro del Marco Estratégico 2020–2030 del Convenio Internacional de Protección Vegetal (IPPC).
“Invitamos a la Reunión Anual de Ministros de Agricultura del G20, el Grupo Banco Mundial y la FAO, entre otros, para aunar esfuerzos a fin de optimizar la cooperación para lograr un plan de acción de varios años para que el GSS propuesto reduzca más eficazmente el impacto de las enfermedades de los cultivos y aumente la seguridad alimentaria mundial”, concluyen los autores. (Fuente: CIAT/DICYT)